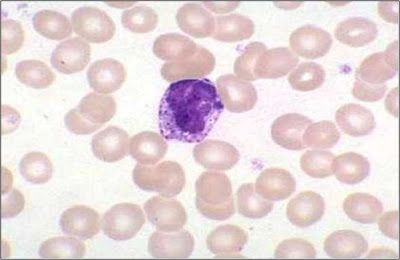

HISTOLOGIA ANIMAL
A Histologia Animal é a parte da Biologia que estuda os tecidos animais.
Tecido é o conjunto de células
que desempenham funções específicas. O tecido pode ser formado por células
iguais ou diferentes entre si, mas todas realizam a mesma função.
Os tecidos animais podem ser
classificados em quatro tipos fundamentais: epiteliais, conjuntivos, muscular e
nervoso.
As glândulas endócrinas não possuem comunicação com o epitélio de origem e lançam suas secreções (hormônios) em capilares sanguíneos. Exemplos: hipófise, tireóide, paratireóide e supra-renais.
As glândulas mistas (anfícrinas ou mesócrinas) são aquelas que apresentam porções endócrinas e porções exócrinas. Exemplos: pâncreas (insulina e suco pancreático), fígado (proteínas e bile), testículos e ovários (hormônios sexuais e espermatozoides/óvulos).
As cartilagens podem ser hialinas, elásticas ou fibrosas.
As cartilagens hialinas são pobres em fibras colágenas e são encontradas no nariz, na traqueia e nas extremidades dos ossos, onde formam as superfícies das articulações.
As cartilagens elásticas apresentam, além das fibras colágenas, grande quantidade de fibras elásticas e são encontradas, por exemplo, no pavilhão da orelha.
As cartilagens fibrosas apresentam grande quantidade de fibras colágenas, sendo mais resistentes do que as outras, ocorrendo, por exemplo, nos discos intervertebrais.
Hemácias (eritrócitos ou glóbulos vermelhos): são as células sanguíneas mais numerosas (cerca de 5 milhões/ml). São produzidas na medula óssea vermelha, perdem o núcleo e organelas e migram para o sangue. Duram de 90 a 120 dias, sendo removidas pelo fígado e baço. Atuam no transporte de O2 e de parte do CO2.
Plaquetas: são porções de megacariócitos (células da medula óssea vermelha), atuando na coagulação sanguínea. Há cerca de 300.000 plaquetas/ml de sangue.

Leucócitos (glóbulos brancos): são os menos numerosos, havendo entre 7.000 a 10.000/ml.
Atuam na defesa do organismo. Em infecções, esse nº pode chegar a 20.000. Há os granulócitos (tipos 1, 2 e 3) e os agranulócitos (tipos 4 e 5):
1 - Neutrófilos: são os mais abundantes, têm núcleo com 3 a 5 lóbulos e atuam na fagocitose.
2 -Acidófilos ou Eosinófilos: têm núcleo com 2 lóbulos e fazem fagocitose. Seu número aumenta, por exemplo, nas alergias e parasitoses intestinais.
3 -Basófilos: têm núcleo grande e inúmeros grânulos citoplasmáticos de heparina (anticoagulante) e histamina (vasodilatador), liberando-os na resposta inflamatória.
4 -Linfócitos: núcleo condensado, ocupando quase toda a célula. Produzem anticorpos. Dividem-se em linfócitos B e T.
5 -Monócitos: têm o núcleo em forma de rim. Atuam na fagocitose de bactérias, vírus e fungos.
Linfa:A linfa é um líquido transparente e esbranquiçado, levemente amarelado ou rosado, alcalino e de sabor salgado, constituído essencialmente pelo plasma sanguíneo, proteínas e por glóbulos brancos. A linfa é transportada pelos vasos linfáticos em sentido unidirecional e filtrada nos linfonodos (também conhecidos como nódulos linfáticos ou gânglios linfáticos). Após a filtragem, é lançada no sangue, desembocando nas grandes veias torácicas.
Tecido Muscular
Este tecido tem origem mesodérmica, tendo capacidade de contração e distensão. Suas células são alongadas e são denominadas miócitos (fibras musculares), dispostas em feixes paralelos e longitudinais e, por meio das miofibrilas presentes no citoplasma, são capazes de se contrair e provocar movimentos. As miofibrilas são organelas cilíndricas, dispostas em feixes longitudinais que preenchem quase totalmente o citoplasma das células musculares, em contacto com as extremidades do sarcolema (a membrana celular
destas células). As miofibrilas são formadas por miosina e actina (proteínas)
Existem três tipos de tecidos musculares: liso, estriado esquelético e estriado cardíaco.
Tecido muscular estriado cardíaco
Suas células são uni ou binucleadas, com núcleo central. Tem estrias transversais e longitudinais. Esse tecido também é chamado de miocárdio e possui contração involuntária, rápida e ritmada.
Contração muscular
A maquinaria contrátil da fibra muscular está formada por cadeias proteicas que se deslizam para encurtar a fibra muscular. Entre elas há a miosina e a actina, que constituem os filamentos grossos e finos, respectivamente. Quando um impulso chega através de uma fibra nervosa, o músculo se contrai.
A contração muscular se dá pelo deslizamento dos filamentos de actina sobre os de miosina. Essa idéia é conhecida como teoria do deslizamento dos filamentos.
Nas pontas dos filamentos de miosina existem pequenas projeções, capazes de formar ligações com certos sítios dos filamentos de actina quando o músculo é estimulado. As projeções da miosina puxam os filamentos de actina como dentes de uma engrenagem, forçando-os a deslizar sobre os filamentos de miosina, o queleva ao encurtamento das miofibrilas e a conseqüente contração da fibra muscular.
Obs.: sarcômero é o espaço entre duas linhas Z.
A faixa I (região clara - só contém actina)
A faixa A (região escura - contém miosina e actina). Permanece inalterada
As linhas Z se aproximam
A faixa H diminui podendo desaparecer
Os filamentos de actina (finos) deslizam entre os filamentos de miosina (grossos)
Na contração forma-se o complexo acto-miosina;
Na contração são consumidos: Glicogênio, Oxigênio, Fosfocreatina, ATP.
Na contração são produzidos: Gás carbônico, Carbono, Hidrogênio, Ozônio, Creatina e ADP.
O neurônio é a unidade estrutural e fisiológica do sistema nervoso.
A maioria dos neurônios é constituída por três partes: corpo celular, axônio e dendritos.
O corpo celular ou pericário é a porção onde se encontra a maior parte do citoplasma e o núcleo. Dele saem várias ramificações, os dendritos, que recebem mensagens dos órgãos dos sentidos ou de outros neurônios e as passam para um músculo, uma glândula ou outro neurônio através de um prolongamento chamado axônio. A passagem do impulso se dá pela região terminal e ramificada do axônio, o telodendro. Feixes de axônios envolvidos por tecido conjuntivo formam os nervos.
Geralmente, os axônios são envolvidos pelas células de Schwann ou oligodendrócitos, que se enrolam várias vezes ao redor do axônio, formando a bainha de mielina. Entre os oligodendrócitos há espaços sem mielina, denominados nódulos de Ranvier.
A neuroglia é a parte do tecido nervoso constituída por três tipos de células:astrócitos, células glia (oligodendrócitos) e células da micróglia (microgliócitos).
Os astrócitos têm a função de nutrir os neurônios; os oligodendrócitos participam da produção de mielina, enquanto que os microgliócitos são responsáveis pela defesa do sistema nervoso.
O Impulso Nervoso
A transmissão do impulso nervoso ocorre numa região chamada de sinapse, onde há a comunicação entre um neurônio e outro. Nessa região não há contato físico entre os neurônios e a passagem do impulso nervoso é facilitada pela ação de neurotransmissores, como por exemplo, a acetilcolina, a noradrenalina, a dopamina e a serotonina.
A condução do impulso nervoso deve-se à atividade da membrana do axônio. Como toda membrana plasmática, a do neurônio apresenta, normalmente, um potencial de repouso, que é mantido graças a um mecanismo que transfere íons Na+ para fora e íons K+ para dentro da célula. Esse mecanismo é chamado bomba de sódio e potássio, que durante seu funcionamento consome energia (transporte ativo). Porém esse bombeamento não é equitativo: para cada três íons sódio bombeados para o líquido extracelular, apenas dois íons potássio são bombeados para o líquido intracelular. Através do funcionamento da bomba de sódio e potássio, a concentração de íons sódio se mantém baixa no interior do neurônio.
Quando o axônio está em repouso, existe uma diferença de potencial igual a -70mV entre o interior do axônio e a superfície externa.
A condução do impulso nervoso consiste numa migração de íons sódio (Na) para o interior e numa migração de íons potássio (K) para o exterior do axônio. Durante essamigração a membrana do axônio muda sua polaridade, a face externa torna-se negativa
em relação à face interna. Desaparece o potencial de repouso e surge um potencial de ação no valor de + 35mV.
no terminal axônico. Quando os impulsos nervosos chegam aos terminais os NT são liberados
por meio de exocitose. A membrana do terminal que libera os NT denomina-se membrana pré-sináptica e a imediatamente vizinha, membrana pós-sináptica. Entre elas há um espaço em torno de 100-500A chamado fenda sináptica. A interação dos NT com a membrana pós-sináptica é realizada por meio de receptores proteicos altamente específicos. Ao interagir com esses receptores, os NTs causam alterações no potencial elétrico pós-sináptico. Além de NT, os neurônios sintetizam outros mediadores (neuromoduladores) (vasopressina, insulina, colicistina, endorfinas, etc.) cujo efeito é o modular (controlar, regular) a transmissão sináptica.
TECIDO EPITELIAL
A principal característica desse tecido é a pouca quantidade de
substância intercelular, fazendo com que suas células fiquem intimamente
unidas, conferindo-lhe grande resistência. O tecido epitelial pode ter origem
embrionária na ectoderme, mesoderme ou endoderme. Suas funções principais são:
proteção, revestimento, secreção, absorção de nutrientes e trocas gasosas.
O tecido epitelial não apresenta
vasos sanguíneos (raras exceções) e sua nutrição se dá por difusão de
substâncias presentes nos capilares localizados no tecido conjuntivo
subjacente, mas possui terminações nervosas.
Tipos de tecidos
epiteliais
Tecido epitelial de revestimento
Também chamado de epitélio de revestimento, reveste o
corpo externamente (epiderme), protegendo-o contra atritos, invasão de
microrganismos ou facilitando a evaporação e, internamente (tubo digestório,
sistemas respiratório e urinário), absorvendo nutrientes, oxigênio, etc.
Esse epitélio pode ser formado
por uma única camada de células (epitélio
simples) ou por várias camadas (epitélio
estratificado). Ocorre também, um terceiro tipo (epitélio pseudo-estratificado), constituído por uma camada de
células com núcleos em alturas diferentes, o que lhe confere uma aparência de
estratificação. Quanto mais fino o epitélio, melhor será sua capacidade de
absorção; quanto mais espesso, melhor a sua capacidade de proteção.
Os epitélios de revestimento
também são classificados de acordo com a forma das suas células superficiais,
que podem ser cúbicas, cilíndricas (prismáticas) ou achatadas, sendo respectivamente
chamados de cúbicos, cilíndricos (prismáticos) e pavimentosos. Ocorre também o epitélio de transição, que reveste a
cavidade da bexiga urinária, cujas células mudam a forma de acordo com a
distensão da mesma.
A maioria dos epitélios
apresenta, entre a superfície e o tecido conjuntivo subjacente, uma região
formada por glicoproteínas e fibras protéicas, chamada de lâmina basal, que promove a adesão entre os dois tecidos.
A origem embrionária dos
epitélios depende de sua localização no corpo, por exemplo: o epitélio que
reveste as cavidades do tubo digestório e das vias respiratórias tem origem
endodérmica; a epiderme tem origem ectodérmica; a pleura, o pericárdio e o
peritônio possuem origem mesodérmica.
Tecido epitelial glandular
Também chamado de epitélio glandular, esse tecido é resultante da multiplicação de células epiteliais especializadas na secreção de substâncias úteis ao organismo, que irão formar as glândulas. As glândulas são divididas em: exócrinas, endócrinas e mistas.
As glândulas exócrinas são aquelas que mantêm comunicação com o epitélio de origem através de um ducto ou canal, lançando suas secreções na superfície ou cavidade de um órgão. Exemplos: glândulas salivares, sudoríparas, sebáceas, lacrimais e mamárias.
As glândulas exócrinas são aquelas que mantêm comunicação com o epitélio de origem através de um ducto ou canal, lançando suas secreções na superfície ou cavidade de um órgão. Exemplos: glândulas salivares, sudoríparas, sebáceas, lacrimais e mamárias.
As glândulas endócrinas não possuem comunicação com o epitélio de origem e lançam suas secreções (hormônios) em capilares sanguíneos. Exemplos: hipófise, tireóide, paratireóide e supra-renais.
As glândulas mistas (anfícrinas ou mesócrinas) são aquelas que apresentam porções endócrinas e porções exócrinas. Exemplos: pâncreas (insulina e suco pancreático), fígado (proteínas e bile), testículos e ovários (hormônios sexuais e espermatozoides/óvulos).
TECIDO CONJUNTIVO
O tecido conjuntivo apresenta células afastadas e grande quantidade de
substância intercelular; é o tecido com maior distribuição no corpo. A origem
do tecido conjuntivo é mesodérmica. As principais funções do tecido conjuntivo
são: preenchimento, sustentação, nutrição dos epitélios, reserva energética,
etc.
A substância intercelular é
formada por fibras e uma parte amorfa chamada matriz extracelular.
Tipos de tecidos
conjuntivos
Tecido conjuntivo propriamente dito (TCPD)
Situado abaixo
do epitélio, tem a função de sustentação e nutrição; entre os órgãos tem função
de preenchimento e ligação entre dois tecidos diferentes.
A porção amorfa do TCPD é formada
por ácido hialurônico e diferentes tipos de células, tais como:
Fibroblastos: produzem
a substância intercelular e originam outras células.
Adipócitos: células que
armazenam gordura.
Macrófagos: fagocitam
microrganismos, restos celulares e partículas que invadem o organismo.
Plasmócitos: fabricam
anticorpos.
Mastócitos: produzem
histamina (substância vasodilatadora) e heparina (substância anticoagulante).
As fibras podem ser de três tipos:
Fibras colágenas: feitas
de colágeno; são resistentes à tração.
Fibras elásticas: feitas
de elastina; cedem à tração, mas voltam à forma original.
Fibras reticulares: feitas de colágeno associado a uma glicoproteína; formam uma rede de
sustentação em certos órgãos.
O tecido conjuntivo propriamente dito pode ser do tipo frouxo ou denso.
O tecido conjuntivo frouxo
apresenta poucas fibras e grande quantidade de substância intercelular, sendo o
mais abundante em nosso corpo. Suas funções são: suporte e nutrição do tecido
epitelial, preenchimento de espaços entre os órgãos e participação na estrutura
de vários órgãos.
O tecido conjuntivo denso
possui maior concentração de fibras, tornando-o mais resistente. É encontrado
na derme, no fígado, no baço, nos ligamentos e tendões.
Tecido conjuntivo adiposo
É muito rico em células adiposas (que acumulam gordura), servindo como reserva energética e proteção contra o frio; envolve diversos órgãos protegendo-os contra traumatismos durante os movimentos. Esse tecido também é encontrado na cavidade de alguns ossos (medula óssea) e formando a hipoderme.
É muito rico em células adiposas (que acumulam gordura), servindo como reserva energética e proteção contra o frio; envolve diversos órgãos protegendo-os contra traumatismos durante os movimentos. Esse tecido também é encontrado na cavidade de alguns ossos (medula óssea) e formando a hipoderme.
Tecido Cartilaginoso (cartilagíneo)
Também chamado de cartilagem, é originado de células jovens chamadas condroblastos, os quais se desenvolvem originando as células cartilaginosas adultas, os condrócitos. A substância intercelular é formada por uma rede de fibras colágenas e elásticas.
O tecido cartilaginoso não possui vasos sanguíneos e sua nutrição é mantida por um tecido conjuntivo denso (pericôndrio).
O tecido cartilaginoso não possui vasos sanguíneos e sua nutrição é mantida por um tecido conjuntivo denso (pericôndrio).
As cartilagens podem ser hialinas, elásticas ou fibrosas.
As cartilagens hialinas são pobres em fibras colágenas e são encontradas no nariz, na traqueia e nas extremidades dos ossos, onde formam as superfícies das articulações.
As cartilagens elásticas apresentam, além das fibras colágenas, grande quantidade de fibras elásticas e são encontradas, por exemplo, no pavilhão da orelha.
As cartilagens fibrosas apresentam grande quantidade de fibras colágenas, sendo mais resistentes do que as outras, ocorrendo, por exemplo, nos discos intervertebrais.
Tecido Ósseo
É o principal
tecido de sustentação, sendo o tecido mais abundante nos ossos. Sua substância
intercelular é formada por fibras colágenas e sais de cálcio. As células do
tecido ósseo são: osteoblastos, osteócitos e oesteoclastos.
Os
osteoblastos produzem a parte orgânica da matriz óssea e também dão origem aos
osteócitos. Os osteócitos são células que se alojam em lacunas ou cavidades,
que são ligadas por canalículos (canais de Havers), formando um sistema chamado
de sistema de Havers ou ósteon. Os
osteoclastos são células multinucleadas originadas dos monócitos (tipo de
leucócito) e participam da reabsorção óssea e de sua remodelação.
Tecido hematopoiético
É o tecido que produz os elementos figurados do sangue. Está dividido em: tecido mieloide ou medula óssea vermelha e tecido linfoide ou linfático.
O tecido mieloide encontra-se na medula óssea vermelha, no interior do canal medular dos ossos. Produz hemácias, plaquetas e os leucócitos (exceto linfócitos).
O tecido linfoide é encontrado na medula óssea e em estruturas isoladas como os linfonodos, o baço, o timo e as tonsilas palatinas (antigas amígdalas). Produz os linfócitos.
Os linfócitos B são produzidos e maturados na medula; os linfócitos T são produzidos na medula e maturados no timo (órgão pequeno que fica próximo ao coração).
O tecido mieloide encontra-se na medula óssea vermelha, no interior do canal medular dos ossos. Produz hemácias, plaquetas e os leucócitos (exceto linfócitos).
O tecido linfoide é encontrado na medula óssea e em estruturas isoladas como os linfonodos, o baço, o timo e as tonsilas palatinas (antigas amígdalas). Produz os linfócitos.
Os linfócitos B são produzidos e maturados na medula; os linfócitos T são produzidos na medula e maturados no timo (órgão pequeno que fica próximo ao coração).
Tecido Sanguíneo
É um tipo especial de tecido conjuntivo em que a substância intercelular, o plasma, é líquida, formada principalmente por água e proteína, servindo como meio de transporte de oxigênio, nutrientes, hormônios e excretas. No plasma estão mergulhados os elementos figurados:hemácias, leucócitos e plaquetas.
Hemácias (eritrócitos ou glóbulos vermelhos): são as células sanguíneas mais numerosas (cerca de 5 milhões/ml). São produzidas na medula óssea vermelha, perdem o núcleo e organelas e migram para o sangue. Duram de 90 a 120 dias, sendo removidas pelo fígado e baço. Atuam no transporte de O2 e de parte do CO2.
Plaquetas: são porções de megacariócitos (células da medula óssea vermelha), atuando na coagulação sanguínea. Há cerca de 300.000 plaquetas/ml de sangue.

Leucócitos (glóbulos brancos): são os menos numerosos, havendo entre 7.000 a 10.000/ml.
Atuam na defesa do organismo. Em infecções, esse nº pode chegar a 20.000. Há os granulócitos (tipos 1, 2 e 3) e os agranulócitos (tipos 4 e 5):
1 - Neutrófilos: são os mais abundantes, têm núcleo com 3 a 5 lóbulos e atuam na fagocitose.
2 -Acidófilos ou Eosinófilos: têm núcleo com 2 lóbulos e fazem fagocitose. Seu número aumenta, por exemplo, nas alergias e parasitoses intestinais.
3 -Basófilos: têm núcleo grande e inúmeros grânulos citoplasmáticos de heparina (anticoagulante) e histamina (vasodilatador), liberando-os na resposta inflamatória.
4 -Linfócitos: núcleo condensado, ocupando quase toda a célula. Produzem anticorpos. Dividem-se em linfócitos B e T.
5 -Monócitos: têm o núcleo em forma de rim. Atuam na fagocitose de bactérias, vírus e fungos.
Linfa:A linfa é um líquido transparente e esbranquiçado, levemente amarelado ou rosado, alcalino e de sabor salgado, constituído essencialmente pelo plasma sanguíneo, proteínas e por glóbulos brancos. A linfa é transportada pelos vasos linfáticos em sentido unidirecional e filtrada nos linfonodos (também conhecidos como nódulos linfáticos ou gânglios linfáticos). Após a filtragem, é lançada no sangue, desembocando nas grandes veias torácicas.
Tecido Muscular
Este tecido tem origem mesodérmica, tendo capacidade de contração e distensão. Suas células são alongadas e são denominadas miócitos (fibras musculares), dispostas em feixes paralelos e longitudinais e, por meio das miofibrilas presentes no citoplasma, são capazes de se contrair e provocar movimentos. As miofibrilas são organelas cilíndricas, dispostas em feixes longitudinais que preenchem quase totalmente o citoplasma das células musculares, em contacto com as extremidades do sarcolema (a membrana celular
destas células). As miofibrilas são formadas por miosina e actina (proteínas)
Existem três tipos de tecidos musculares: liso, estriado esquelético e estriado cardíaco.
Tipos de tecidos musculares
Tecido muscular liso
É formado por células com núcleo único e central, sem estrias transversais. Ocorre nas paredes dos órgãos ocos (tubo digestório, útero, bexiga, vasos sanguíneos, brônquios e (bronquíolos), envolvendo as glândulas e presos aos pelos. Sua contração é lenta einvoluntária (independe de nossa vontade).
Tecido muscular estriado esquelético
É formado por células multinucleadas, com núcleos periféricos, apresentando estrias longitudinais e transversais, com disposição regular, formando faixas claras e escuras. Forma os músculos que revestem os ossos; está presente no abdome, sob a pele do rosto e presosao globo ocular. Sua contração é rápida e voluntária (depende de nossa vontade).Suas células são uni ou binucleadas, com núcleo central. Tem estrias transversais e longitudinais. Esse tecido também é chamado de miocárdio e possui contração involuntária, rápida e ritmada.
Contração muscular
A maquinaria contrátil da fibra muscular está formada por cadeias proteicas que se deslizam para encurtar a fibra muscular. Entre elas há a miosina e a actina, que constituem os filamentos grossos e finos, respectivamente. Quando um impulso chega através de uma fibra nervosa, o músculo se contrai.
A contração muscular se dá pelo deslizamento dos filamentos de actina sobre os de miosina. Essa idéia é conhecida como teoria do deslizamento dos filamentos.
Nas pontas dos filamentos de miosina existem pequenas projeções, capazes de formar ligações com certos sítios dos filamentos de actina quando o músculo é estimulado. As projeções da miosina puxam os filamentos de actina como dentes de uma engrenagem, forçando-os a deslizar sobre os filamentos de miosina, o queleva ao encurtamento das miofibrilas e a conseqüente contração da fibra muscular.
Obs.: sarcômero é o espaço entre duas linhas Z.
A faixa I (região clara - só contém actina)
A faixa A (região escura - contém miosina e actina). Permanece inalterada
As linhas Z se aproximam
A faixa H diminui podendo desaparecer
Os filamentos de actina (finos) deslizam entre os filamentos de miosina (grossos)
Na contração forma-se o complexo acto-miosina;
Na contração são consumidos: Glicogênio, Oxigênio, Fosfocreatina, ATP.
Na contração são produzidos: Gás carbônico, Carbono, Hidrogênio, Ozônio, Creatina e ADP.
Tecido nervoso
O tecido nervoso é especializado na condução e transmissão dos impulsos nervosos. Além de receber as sensações do meio ambiente; o tecido nervoso coordena as atividades de vários sistemas, garantindo o bom funcionamento do organismo. Na estrutura do tecido nervoso destacam-se dois tipos de células: os neurônios e as células da neuroglia (glia). O neurônio é a unidade estrutural e fisiológica do sistema nervoso.
A maioria dos neurônios é constituída por três partes: corpo celular, axônio e dendritos.
O corpo celular ou pericário é a porção onde se encontra a maior parte do citoplasma e o núcleo. Dele saem várias ramificações, os dendritos, que recebem mensagens dos órgãos dos sentidos ou de outros neurônios e as passam para um músculo, uma glândula ou outro neurônio através de um prolongamento chamado axônio. A passagem do impulso se dá pela região terminal e ramificada do axônio, o telodendro. Feixes de axônios envolvidos por tecido conjuntivo formam os nervos.
Geralmente, os axônios são envolvidos pelas células de Schwann ou oligodendrócitos, que se enrolam várias vezes ao redor do axônio, formando a bainha de mielina. Entre os oligodendrócitos há espaços sem mielina, denominados nódulos de Ranvier.
A neuroglia é a parte do tecido nervoso constituída por três tipos de células:astrócitos, células glia (oligodendrócitos) e células da micróglia (microgliócitos).
Os astrócitos têm a função de nutrir os neurônios; os oligodendrócitos participam da produção de mielina, enquanto que os microgliócitos são responsáveis pela defesa do sistema nervoso.
A transmissão do impulso nervoso ocorre numa região chamada de sinapse, onde há a comunicação entre um neurônio e outro. Nessa região não há contato físico entre os neurônios e a passagem do impulso nervoso é facilitada pela ação de neurotransmissores, como por exemplo, a acetilcolina, a noradrenalina, a dopamina e a serotonina.
A condução do impulso nervoso deve-se à atividade da membrana do axônio. Como toda membrana plasmática, a do neurônio apresenta, normalmente, um potencial de repouso, que é mantido graças a um mecanismo que transfere íons Na+ para fora e íons K+ para dentro da célula. Esse mecanismo é chamado bomba de sódio e potássio, que durante seu funcionamento consome energia (transporte ativo). Porém esse bombeamento não é equitativo: para cada três íons sódio bombeados para o líquido extracelular, apenas dois íons potássio são bombeados para o líquido intracelular. Através do funcionamento da bomba de sódio e potássio, a concentração de íons sódio se mantém baixa no interior do neurônio.
Quando o axônio está em repouso, existe uma diferença de potencial igual a -70mV entre o interior do axônio e a superfície externa.
A condução do impulso nervoso consiste numa migração de íons sódio (Na) para o interior e numa migração de íons potássio (K) para o exterior do axônio. Durante essamigração a membrana do axônio muda sua polaridade, a face externa torna-se negativa
em relação à face interna. Desaparece o potencial de repouso e surge um potencial de ação no valor de + 35mV.
Tipos de Sinapses
Sinapse química
Os neurônios comunicam-se uns com os outros neurônios ou com as células efetuadoras (células musculares ou glandulares) por meio de mediadores químicos denominados neurotransmissores (NT) (acetilcolina, histamina). Os NT são sintetizados pelos próprios neurônios e armazenados dentro de vesículas. Essas vesículas concentram-se no terminal axônico. Quando os impulsos nervosos chegam aos terminais os NT são liberados
por meio de exocitose. A membrana do terminal que libera os NT denomina-se membrana pré-sináptica e a imediatamente vizinha, membrana pós-sináptica. Entre elas há um espaço em torno de 100-500A chamado fenda sináptica. A interação dos NT com a membrana pós-sináptica é realizada por meio de receptores proteicos altamente específicos. Ao interagir com esses receptores, os NTs causam alterações no potencial elétrico pós-sináptico. Além de NT, os neurônios sintetizam outros mediadores (neuromoduladores) (vasopressina, insulina, colicistina, endorfinas, etc.) cujo efeito é o modular (controlar, regular) a transmissão sináptica.
Sinapse elétrica
Comunicação nervosa que dispensa mediadores químicos; a neurotransmissão é estabelecida através da passagem direta de íons por meio das junções abertas ou comunicantes (gap junctions) onde os canais iônicos ficam acoplados. A transmissão da informação é muito rápida, mas não oferece versatilidade quanto à possibilidade de modulação da neurotransmissão. São particularmente úteis nas vias reflexas rápidas e nas respostas sincrônicas de alguns neurônios do SNC.
Ato reflexo e arco reflexo
Os atos reflexos ou simplesmente reflexos são respostas automáticas, involuntárias a um estímulo sensorial. O estímulo chega ao órgão receptor, é enviado à medula através de neurônios sensitivos ou aferentes (chegam pela raiz dorsal). Na medula, neurônios associativos recebem a informação e emitem uma ordem de ação através dos neurônios motores (saem da medula através da raiz ventral). Os neurônios motores ou eferentes chegam ao órgão efetor que realizará uma resposta ao estímulo inicial. Esse caminho seguido pelo impulso nervoso e que permite a execução de um ato reflexo é chamado arco reflexo.